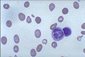

![]() Tele
laboratorio
Tele
laboratorio
TELE DIAGNÓSTICO DE LABORATORIO
PASOS A SEGUIR PARA ACCEDER A ESTE SERVICIO
1) Capture la imagen a su PC ( con un lente capturador de imágenes acoplado a su microscopio)
2) Grábelo en formato JPG
3) Incluya los siguientes datos del paciente: iniciales, sexo y edad, y si es posible una breve descripción de los signos y síntomas principales del paciente
4) Incluya el nombre del establecimiento desde donde se envía y el del profesional responsable.
5) La información mándela por E-mail
6) Vd, recibira en su E-mail el telediagnóstico en el trancurso de las 24 horas siguientes
| CASO
1 Anemia Megaloblastica |
 |
CASO 2 Anemia Aplástica |
 |
| Sangre Perif. Giemsa. x100 y x1000 |
|
Médula
osea Hematox eoxina x100 y x200 |
 |